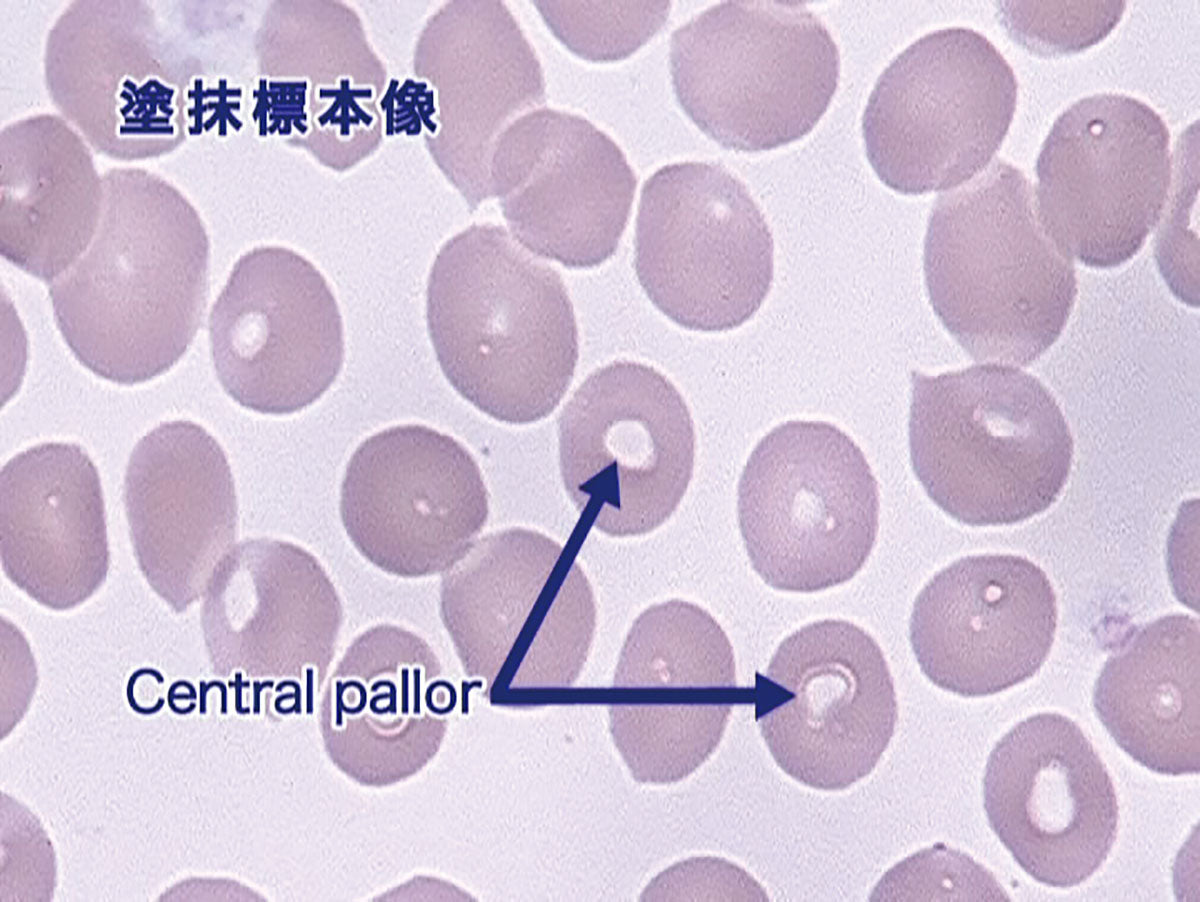
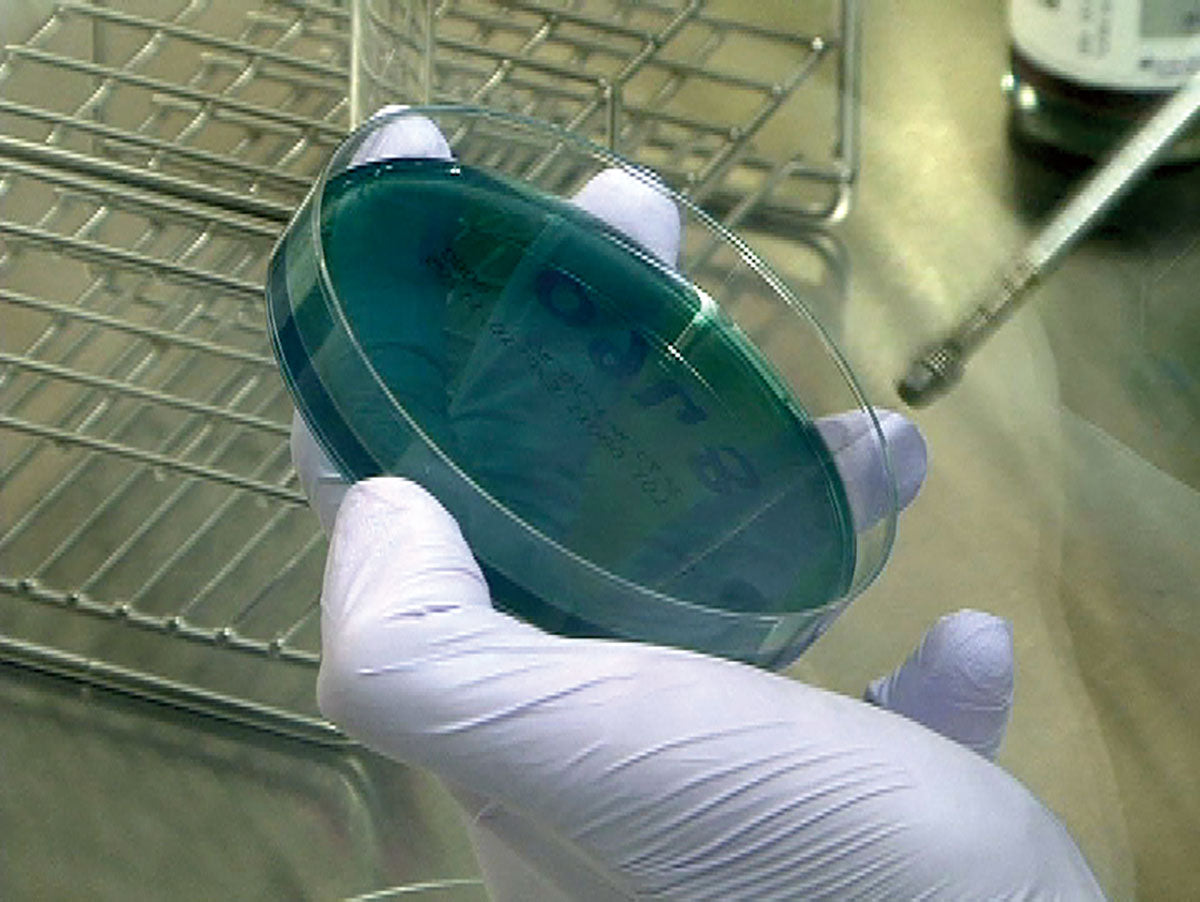

-
- 定価:¥352,000
- オンラインショップ価格:¥334,400
『目で見る新しい臨床検査』が生まれ変わりました!複雑な検査の原理や検査方法、そして検査結果が示す臨床上の意義を、豊富な資料映像と画像に加え、CGを駆使してシンプルでわかりやすく解説しています。
[Vol.01] 一般検査
[Vol.02] 血液学検査
[Vol.03] 血液生化学検査
[Vol.04] 代謝・内分泌検査
[Vol.05] 臓器機能検査
[Vol.06] 微生物学検査
[Vol.07] 免疫血清検査
[Vol.08] 病理検査
[Vol.09] 生理機能検査I
[Vol.10] 生理機能検査II
-
- 定価:¥35,200
- オンラインショップ価格:¥33,440
一般検査は、今日でもスクリーニング検査として広く行われています。尿試験紙法、尿沈渣検査、便検査、穿刺液検査について、検査の方法やポイント、また臨床上の意義などを解説します。
Index
●尿の生成
●尿検査
●尿試験紙法
〇尿比重・浸透圧
〇尿pH
〇尿蚤白
〇尿糖(ブドウ糖)
〇尿ケトン体
〇亜硝酸塩・尿白血球
●尿沈渣検査
〇赤血球
〇円柱
〇結晶
●便検査
〇便の肉眼的性状
〇便の顕微鏡的検査
〇便潜血検査
●穿刺液検査
〇脳脊髄液
〇腹水・胸水 -
- 定価:¥35,200
- オンラインショップ価格:¥33,440
血液学検査は、血液中の細胞成分を対象とした検査です。血球数算定、形態検査、骨髄検査、凝固線溶検査について、検査の方法やポイント、また臨床上の意義などを解説します。
Index
●血球数算定(血算)
〇赤血球の血算値
〇白血球の血算値
〇血小板の血算値
●血液細胞(血球)形態検査
〇赤血球の形態
〇白血球の形態
〇血小板の形態
●骨髄検査
〇骨髄造血細胞の形態
〇異常血液細胞(腫瘍性細胞)
●凝固線溶検査
〇血栓の形成と血液凝固過程
〇主な凝固線溶検査
●資料編 -
- 定価:¥35,200
- オンラインショップ価格:¥33,440
血液蛋白検査、酵素検査、電解質・重金属検査、非窒素成分検査などについて検査の方法やポイント、また臨床上の意義などを解説します。
Index
●血清蛋白検査
●非蛋白窒素成分
●血清酵素検査
●生体色素(ビリルビン)
●電解質・血漿浸透圧
●血清カルシウム(Ca)
●血清鉄(Fe) -
- 定価:¥35,200
- オンラインショップ価格:¥33,440
代謝検査では、糖尿病に関連する糖代謝検査や、脂質異常症に関連する脂質代謝検査などについて解説します。内分泌検査では、ホルモン機能検査(視床下部-下垂体系、下垂体-甲状腺系、副甲状腺系、副腎系、性腺系)などについて解説します。
Index
●代謝検査
〇糖代謝に関連する検査
〇脂質代謝に関連する検査
〇メタポリックシンドローム
●内分泌検査
〇視床下部-下垂体系機能検査
〇下垂体-甲状腺系機能検査
〇副甲状腺機能検査
〇下垂体-副腎皮質系機能検査
〇副腎髄質機能検査
〇下垂体-性腺系機能検査 -
- 定価:¥35,200
- オンラインショップ価格:¥33,440
臓器機能検査では、主に肝臓、膵臓、腎臓の機能検査について、検査の方法やポイント、また異常値が示す臨床上の意義などを解説します。
Index
●肝機能検査
〇症例1-A型急性肝炎
〇症例2-B型慢性肝炎
〇症例3-非アルコール性脂肪性肝疾患(NAFLD)
〇症例4-原発性胆汁性肝硬変(PBC)
●膵機能検査
〇症例1-急性膵炎
●腎機能検査
〇症例1-ネフローゼ症侯群
〇症例2-糖尿病性腎症
●心筋マーカー
〇トロポニン(TnT、TnI)
〇心臓型脂肪酸結合蛋白(H-FABP)
〇クレアチンキナーゼ(CK-MB)
〇ミオグロビン
〇ミオシン軽鎖
●腫瘍マーカー
〇AFP
〇PIVKA-II
〇PSA
〇CA19-9
〇CEA
〇CA125 -
- 定価:¥35,200
- オンラインショップ価格:¥33,440
微生物学検査は、感染症の診断に欠かすことのできない検査です。塗抹検査や培養検査、迅速検査(主に遺伝子検査)について検査の方法やポイントを中心に、検体の取り扱い、感染症と原因微生物、薬剤感受性などを解説します。
Index
●微生物学検査の流れ
〇検体採取
〇塗抹検査(グラム染色)
〇培養検査
〇同定検査-抗菌薬感受性検査-迅速検査
●代表的な起炎菌の細菌学的特徴と主な感染症
〇グラム陰性球菌 GPC
〇グラム陰性球菌 GPR
〇グラム陰性球菌 GNC
〇グラム陰性球菌 GNR
〇真菌 -
- 定価:¥35,200
- オンラインショップ価格:¥33,440
免疫血清検査では、感染症検査、アレルギー検査、抗核抗体検査、血液型検査などについて、検査の方法やポイント、また臨床上の意義などを解説します。
Index
●免疫の基本的な仕組み
〇細胞性免疫
〇体液性免疫
〇免疫グロブリン
●感染症の検査
〇梅毒
〇肝炎
〇後天性免疫不全症候群(エイズ)
〇結核
●アレルギーの検査
〇I型アレルギー
●自己免疫疾患の検査
〇抗核抗体
〇関節リウマチ
●血液型の検査
〇ABO式血液型
〇Rh式血液型
〇不規則抗体 -
- 定価:¥35,200
- オンラインショップ価格:¥33,440
病理検査では、病理組織検査、細胞診検査について、材料の採取から染色までの標本の作製過程、観察のポイントや臨床上の意義について解説します。また病理解剖については、その目的と意義などを見ていきます。
Index
●病理組織検査
〇標本の作製(固定、切り出し、包埋、薄切、染色)
〇免疫染色
●術中迅速診断
●細胞診検査
〇細胞の採取
〇塗抹法
〇固定法
〇染色
〇鏡検
●病理解剖 -
- 定価:¥35,200
- オンラインショップ価格:¥33,440
脳波検査、筋電図検査では、画像検査などではわからない脳の機能を観察できます。脳波検査では、電極装着と導出法、脳波検査の実際、異常波などについて、筋電図検査では、針筋電図、末梢神経伝導速度、体性感覚誘導電位などについて、検査の方法やポイント、また臨床上の意義などを解説します。
Index
●脳波検査
〇脳波とは
〇電極の装着と導出法
〇脳波検査の実際
〇突発性異常波(棘波、鋭波)
〇非突発性異常波
〇平坦脳波
●筋電図検査
〇筋収縮の仕組み
〇筋電図検査の実際 -
- 定価:¥35,200
- オンラインショップ価格:¥33,440
呼吸機能検査では、スパイロメトリー、肺気量分画、動脈血ガス分析などについて、循環機能検査では心電図、脈波、24時間血圧計などについて、検査の方法やポイント、また臨床上の意義などについて解説します。
Index
●呼吸機能検査
●循環機能検査